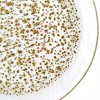

Sponsored

Slickblue Elegant Pebble Pattern Glass Accent Plate - 7" (in 3 Color Options)
$44.99
In Stock
Eligible for registries and wish lists
Sponsored
About this item
Highlights
- Clear, Emerald, and Indigo Color Options
- Creates Unique Shimmering Effect
- Ideal for Dinner Parties and Events
- Dynamic Atmosphere with Accent Plates
- Durable and High-Quality Glass Material
Description
Elevate your dining experience with this fresh and sleek collection featuring a distinctive design and rich aesthetic. The genuine pebble pattern on the clear or colored glass surface creates a unique shimmering effect that adds elegance to any table setting. Available in three stunning color combinations—Clear and Gold, Emerald and Gold, and Indigo and Bronze—this 7-inch accent plate is perfect for adding a dynamic atmosphere to your dinner parties. Mix and match with other pieces in the collection to create a captivating and sophisticated look. Crafted from durable, high-quality glass, this plate is ideal for modern and elegant table settings.
Features: Round (shape)
Number of Pieces: 1
Overall Width: 7 inches
Service For: 1
Material: Glass
Care & Cleaning: Care Instructions Not Provided
TCIN: 93144228
UPC: 657561457318
Origin: imported
The above item details were provided by the Target Plus™ Partner. Target does not represent or warrant that this information is accurate or complete. On occasion, manufacturers may modify their items and update their labels.
We recommend that you do not rely solely on the information presented. If you have a specific question about this item, you may consult the item's label, contact the manufacturer directly or call Target Guest Services at 1-800-591-3869.
If the item details aren’t accurate or complete, we want to know about it.
Shipping details
Estimated ship dimensions: 3 inches length x 8 inches width x 8 inches height
Estimated ship weight: 1 pounds
This item cannot be shipped to the following locations: American Samoa (see also separate entry under AS), Guam (see also separate entry under GU), Northern Mariana Islands, Puerto Rico (see also separate entry under PR), United States Minor Outlying Islands, Virgin Islands, U.S., APO/FPO, Alaska, Hawaii
item ships from third party seller: SlickBlue LLC
Return details
This item can be returned to any Target store or Target.com.
This item must be returned within 30 days of the date it was purchased in store, shipped, delivered by a Shipt shopper, or made ready for pickup.
See the return policy for complete information.
WARNING: This product contains a chemical known to the State of California to cause cancer or birth defects or other reproductive harm For more information, go to https://www.p65warnings.ca.gov/


















